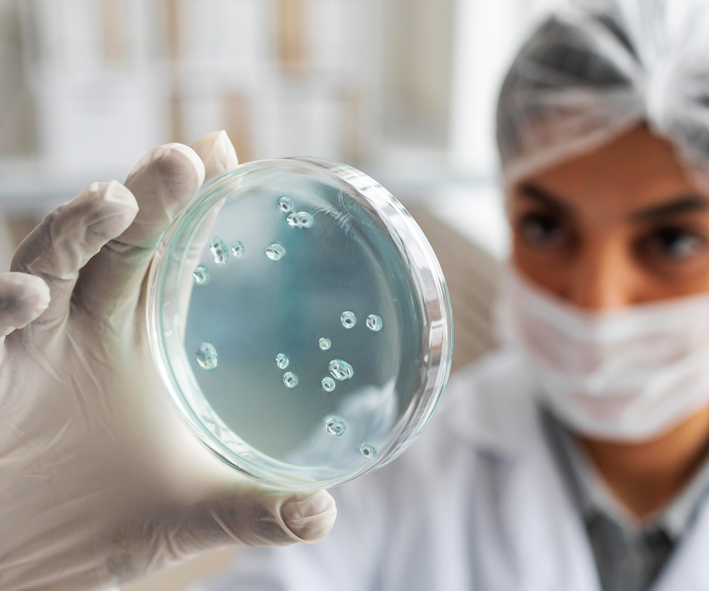

Social
"Food Quality & Safety"
ISO 22000 | HACCP | GMP
Before 1862, most people thought germs grew out of nowhere until scientist Louis Pasteur proved them wrong. He boiled broth in flasks and closed them; no organisms grew in them. He opened them, dust entered the flasks and organisms grew in some of them.
He took some of the flasks up to the mountains and opened them there. Only a few of the flasks had organisms growing in them, showing that air in the mountains had less dust and fewer organisms.
He used unclosed swan neck flasks and outside air could enter the flasks via a long curving necks that made dust particles stick to the necks. Nothing grew in the broths unless the flasks were tilted, making the liquid touch the contaminated walls of the neck. This meant that microorganisms could get into the broth through dust that settled along the neck and did not come spontaneously in the broth or out of the thin air. His discoveries led to milk, beer, wine and even eggs being heated at temperatures of between 60°C and 100°C, allowing them to have a much longer shelf life. This process is today named after him: Pasteurisation.
MY CO2 food quality and safety assessment and measurement technologies ensure that your food production systems not only comply with regulatory guidelines but will help you keep your customers happy and healthy.
He used unclosed swan neck flasks and outside air could enter the flasks via a long curving necks that made dust particles stick to the necks. Nothing grew in the broths unless the flasks were tilted, making the liquid touch the contaminated walls of the neck. This meant that microorganisms could get into the broth through dust that settled along the neck and did not come spontaneously in the broth or out of the thin air. His discoveries led to milk, beer, wine and even eggs being heated at temperatures of between 60°C and 100°C, allowing them to have a much longer shelf life. This process is today named after him: Pasteurisation.
MY CO2 food quality and safety assessment and measurement technologies ensure that your food production systems not only comply with regulatory guidelines but will help you keep your customers happy and healthy.

Surface Swabbing / Air Testing
In food handling environments, these are essential early warning tests to detect and get rid of pathogenic micoorganisms before contamination happens. Surface swabs will be performed on employees' hands, utensils, benches or any other area that food being processed will likely come into contact with. Further, air quality tests using bioaerosol impactors or the sedimentation method (agar plates placed in the environment for bacteria to land on them and reveal themselves) will identify airborne microbes.

ISO 22000 Food Safety Management System Certification and Hazard Analysis and Critical Control Point (HACCP)
ISO 22000 is a Food Safety Management System (FSMS) that can be applied by any organisation in the food industry. HACCP is an internationally recognized system that ensures food safety at all stages of the food chain. These standards help your organisation identify and control food safety hazards. They increase confidence over product safety and quality at all levels.
Microbiology and Their Toxins
To ensure your food products are safe, we conduct microbiological tests according to methods such as USP, BP, FDA-BAM, AOAC, APHA AS/NZS, ISO. These tests ensure you comply with regulations and keep your customers safe from health risks.

Drinking & Ultrapure Water Testing
We provide accreditated drinking water testing services compliant with Ministry of Health (MOH) 25th & 25th A schedule and WHO drinking water guidelines. The trace elements can be detected down to parts-per-billion levels using ICPMS.

Shelf-Life Study
We adopt the National Pharmaceutical Control Bureau's methodology to conduct real time and accelerated shelf-life testing.

Halal, GMO, and Bacterial and Virus Testing
Real-time PCR technique is used to test for foreign DNA, porcine, genetically modified organisms, identification of bacteria such as salmonella and viruses.

Food Additives and Mineral Contaminants Testing
We test for colouring substances, ester profiles, antioxidants, sweetening agents, added nutrients such as vitamins, and preservatives. Mineral contamination, over time, can cause serious illness or fatality among consumers and this test will yield detailed mineral profiles.

Fertilizer, Soil and Plant Testing
For agriculturists to be certain that their crops get the right amounts of nutrients, a soil analysis will decide how much fertilizer is needed. Plant testing will be carried out to measure results in practice and even a study of how the fertilizer is applied is done to determine optimum nutrient supply to crops.

Nutritional Fact Testing
Our tests of nutritional facts and labels meet USFDA, EU Directive, Australia, China, Singapore and other statutory requirements. We measure serving sizes, percentages of daily nutrient requirements and nutrient reference values for easy consumer reference.

Food Packaging Materials Testing
This is to examine substances like Arsenic, Chromium, Lead, Copper, Biphenol A etc. from packaging which intended to come into contact with food are not transferred to food in quantities large enough to endanger human health.

Animal Feed Testing
This test ensures that nutrients in animal feed are certifiably sufficient while contaminants and veterinary drugs are kept to the minimum legal limits.

Edible Oil Testing
We are licensed to test edible oil and petrochemical products under Malaysia Palm Oil Board and Federation of Oils, Seeds and Fats Association. We provide same-day delivery and accurate results to meet your surveyor and customer's shipping schedule.

Cosmetics and Toiletries Testing
For cosmetics and toiletries products that you wish to bring to Malaysia, we can certify the efficacy of the preservatives, validate the absence of prohibited and controlled ingredients, verify the flash point, microbial control limit, heavy metal level, in vitro skin toxicity and much more.

Food Contaminants Analysis
This service help measure contaminants like allergens, pesticide and veterinary drug residues and a host of other adulterants in food products. Such analyses keep you compliant with regulations in your raw ingredients, semi-manufactured foods and final products. We assist to check on local and international legislation on permitted quantities of banned substances in food.

Pharmaceutical Drugs and Traditional Herbs Testing
The testing are complied to monograph of latest edition of BP, USP and EP etc. We are recognized by BPFK covers scope of heavy metal, microbial contaminants, uniformity of weight and disintegration of traditional herbs products. Besides, we are also one of overseas laboratories accreditated by Health Sciences Authority (HSA Singapore).
MOH BPFK MAL registration >>
MOH BPFK MAL registration >>

Health Cert and Free Sales
Different product require different test parameters. Commonly required will be microbiological, preservative, and heavy metal tests. Microbiological test such as Total Bacteria Count, Mold & Yeast Count, Coliform, and other pathogenic bacteria are the core parameters. Also heavy metal such as Mercury, Lead, Cadmium, Arsenic and preservatives such as Benzoic Acid are also commonly required for Health Certificate Application and Free Sales Application.
We are an approved laboratory by Ministry of Health to carryout analysis for export orientated samples.
MOH Certification letter >>
Different product require different test parameters as most commonly is microbiological, preservative, and heavy metal tests. Microbiological test such as Total Bacteria Count, Mold & Yeast Count, Coliform, and other pathogenic bacteria are the core parameters. Heavy metal sure as Mercury, Lead, Cadmium, Arsenic and preservative such as Benzoic Acid are common for Health Certificate Application and Free Sales Application. Our laboratory will ensure fast turnaround time to cater your Health cert application and Free Sales application needs.
Health Cert Application >>
Free Sales Application >>
We are an approved laboratory by Ministry of Health to carryout analysis for export orientated samples.
MOH Certification letter >>
Different product require different test parameters as most commonly is microbiological, preservative, and heavy metal tests. Microbiological test such as Total Bacteria Count, Mold & Yeast Count, Coliform, and other pathogenic bacteria are the core parameters. Heavy metal sure as Mercury, Lead, Cadmium, Arsenic and preservative such as Benzoic Acid are common for Health Certificate Application and Free Sales Application. Our laboratory will ensure fast turnaround time to cater your Health cert application and Free Sales application needs.
Health Cert Application >>
Free Sales Application >>

Chemical and Heavy Metal
Heavy metals such as mercury, arsenic, lead, cadmium, tin and antimony are toxic metals and harmful to all living organism. Accumulation of such elements over time can cause serious illness or fatality. To ensure it's safe, we apply AOAC method to determine heavy metal residue in food.
Heavy metals such as mercury, arsenic, lead, cadmium, tin and antimony are toxic metals and harmful to all leaving life because their accumulation over time can cause serious illness or fatality. European Union EN71-Part 3 (Migration of heavy metal) has strict guideline to prevent heavy metal such as lead migrate from toy to kids where lead is often use as shining agent in toy. The lead permissible limit in toy has been reduced to 50 ppm recently.
Similarly, emission of air pollutant such as heavy metal through incomplete combustion manufacturing process will threaten our environment because unlike other organic pollutants, heavy metals do not decay over time. USEPA and NIOSH sampling method often use to determine heavy metal residue in air.
Heavy metals such as mercury, arsenic, lead, cadmium, tin and antimony are toxic metals and harmful to all leaving life because their accumulation over time can cause serious illness or fatality. European Union EN71-Part 3 (Migration of heavy metal) has strict guideline to prevent heavy metal such as lead migrate from toy to kids where lead is often use as shining agent in toy. The lead permissible limit in toy has been reduced to 50 ppm recently.
Similarly, emission of air pollutant such as heavy metal through incomplete combustion manufacturing process will threaten our environment because unlike other organic pollutants, heavy metals do not decay over time. USEPA and NIOSH sampling method often use to determine heavy metal residue in air.

Preservative and Pesticides Testing
Preservatives are synthetic or natural substances which are added into products during production process to prevent decomposition of food products. We provide an accredited testing service to examine preservative and pesticide levels for both consumer and industrial products.
A preservative is a synthetic or naturally substance which is added into products during production process to prevent decomposition by undesirable chemical or physical changes and microbial growth.
The most commonly used preservatives are Sodium Benzoate, Sulfur Dioxide, Sorbic Acid and etc.
Whereas the pesticide is any chemical substance or mixture of chemical substances or biological agent to prevent, control and mitigate any pest which is harmful to the product. Indeed extensive use of any preservative and pesticide will place a potential toxicity to consumer and others leaving life on the globe.
We provide accredited testing services to examine the preservative and pesticide for both consumer and industrial products.
A preservative is a synthetic or naturally substance which is added into products during production process to prevent decomposition by undesirable chemical or physical changes and microbial growth.
The most commonly used preservatives are Sodium Benzoate, Sulfur Dioxide, Sorbic Acid and etc.
Whereas the pesticide is any chemical substance or mixture of chemical substances or biological agent to prevent, control and mitigate any pest which is harmful to the product. Indeed extensive use of any preservative and pesticide will place a potential toxicity to consumer and others leaving life on the globe.
We provide accredited testing services to examine the preservative and pesticide for both consumer and industrial products.


